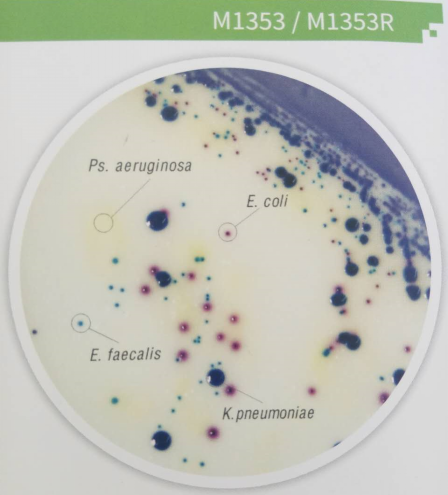
尿道病原菌显色培养基

9 年
手机商铺
公司新闻/正文
205 人阅读发布时间:2018-09-11 16:29
尿路感染又称泌尿系统感染,是尿路上皮受细菌侵入导致的炎症反应,通常伴随有菌尿和脓尿。尿路感染根据感染部位分为上尿路感染和下尿路感染;根据两次感染之间的关系可分为孤立或散发性感染和复发性感染,后者又可分为再感染和细菌持续存在,细菌持续存在也称为复发;根据感染发作时的尿路状态又可分为单纯性尿路感染、复杂性尿路感染及尿脓毒血症。尿路感染常多发于女性,尤其多发于性生活活跃期及绝经后女性。
尿路感染临床常表现为:急性尿道综合征(如尿频、尿急、尿痛及耻骨上不适)、慢性尿道综合征、无症状性菌尿、肾脓肿和肾周脓肿。尿路感染95%以上由单一细菌引起,最常见的是大肠杆菌,其次为腐生葡萄球菌、克雷伯氏菌、奇异变形杆菌、铜绿假单胞菌或粪肠球菌。大肠杆菌可导致无症状菌尿或无并发症的尿感。变形杆菌、产气肠杆菌、克雷白肺炎杆菌、铜绿假单胞菌、粪链球菌等见于再感染、留置导尿管、有并发症之尿路感染者;白色念珠菌、新型隐球菌感染多见于糖尿病及使用糖皮质激素和免疫抑制药的病人及肾移植后;金黄色葡萄球菌多见于皮肤创伤及吸毒者引起的菌血症和败血症;病毒、支原体感染虽属少见,近年来有逐渐增多趋向。多种细菌感染见于留置导尿管、神经源性膀胱、结石、先天性畸形和阴道,肠道、尿道瘘等。
HiMedia公司(国际知名微生物培养基生产商)生产的尿道病原菌显色培养基(货号:MV1353)及其改良型(货号MV1418)用于鉴定和验证尿道病原菌。MV1353也可用于水、食品、环境样本的细菌鉴别。MV1418则更适用于含有较多变形杆菌的样本。培养基中的显色底物被肠球菌、大肠杆菌和大肠菌群产生的酶特异性裂解。蛋白胨所含有的氨基酸,如苯丙氨酸和色氨酸的存在有助于检测色氨酸脱氨酶活性,以提示是否存在变形杆菌属、摩根氏菌属、普罗威登斯菌属。

尿道病原菌显色培养基在国际上得到广泛应用,如Annie Rajaratnam等人的孕妇无症状菌尿和相关危险因素的诊断研究(Annie Rajaratnam,corresponding author,Neha Maria Baby, Thomas .S. Kuruvilla. Diagnosis of Asymptomatic Bacteriuria and Associated Risk Factors Among Pregnant Women in Mangalore, Karnataka, India.journal of clinical and diagnostic research[J].2014,8(9):23-25);R Parveen等人就Hicrome UTI agar显色培养基、CLED 培养基和其他常规培养基在泌尿道病原体检测中的应用进行了阐述(R Parveen, SK Saha, SM Shamshuzzaman, AL Rashid. Detection of Uropathogens by Using Chromogenic Media (Hicrome UTI agar), CLED agar and other Conventional Media.Faridpur Medical College Journal[J].2011,6(1): 46-50.)